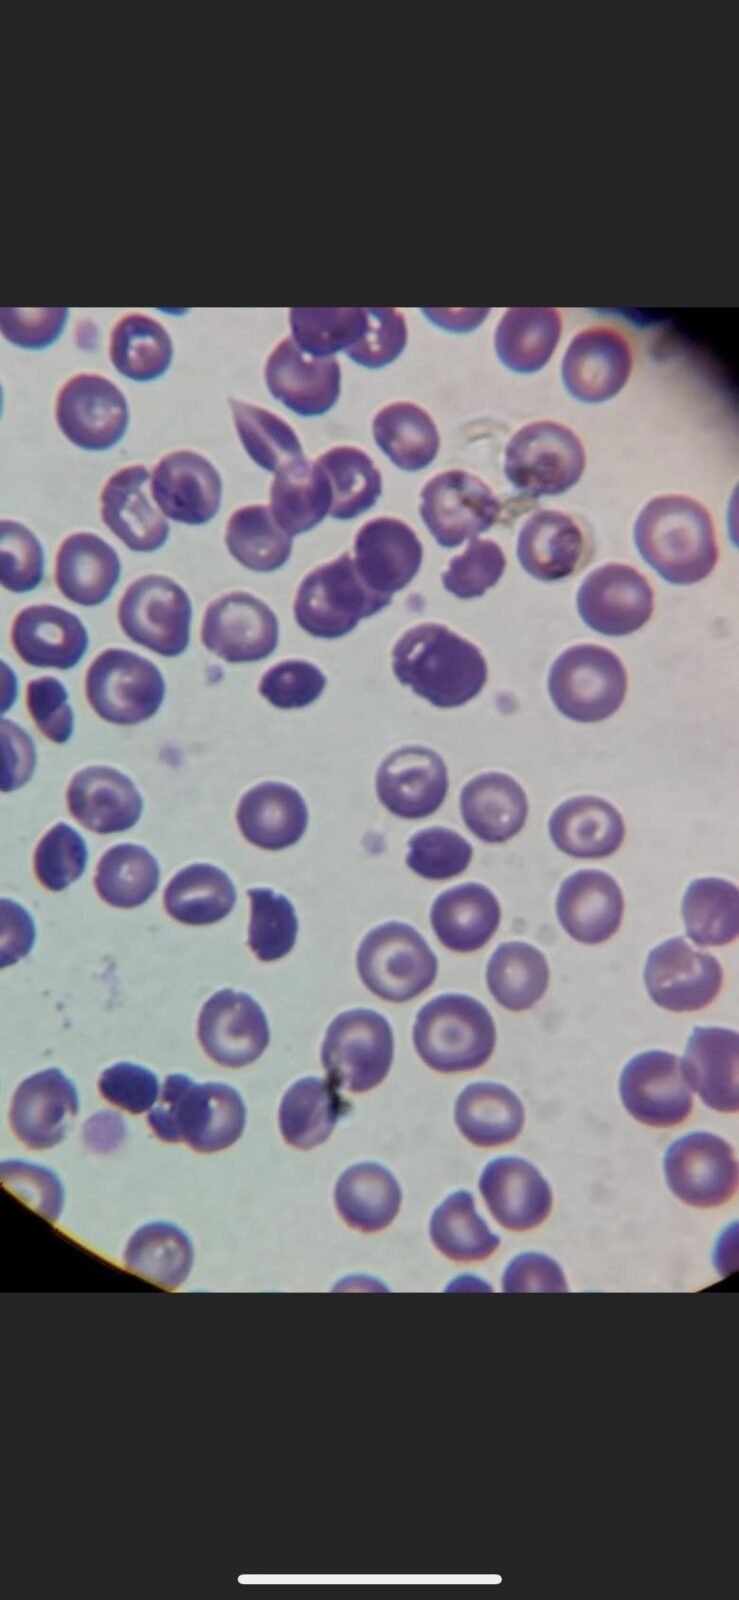
E559D1E0-BA82-466F-99D4-63752568DDAD

MSC Home › Forums › Stump the Chump › Histology of the week!
-
Histology of the week!
-
Anonymous
Deleted UserJuly 27, 2020 at 12:57 pm@pstone the image on the left looks like a bunch of target cells seen in diseases like thalassemia, HbC, liver disease, asplenia (HALT) but I’m holding back a little bit here because they look a little more basophilic than would be normally appreciated
-
Anonymous
Deleted UserJuly 29, 2020 at 2:29 pm@pstone this one is stumping me. Here’s my thought process so far: it looks like there is lymphocyte with lipid droplets or vacuoles. I think this is hinting at bone marrow location. After that I’m stuck!
-
The right looks like a monocyte. But I am also stumped as well!
Viewing 1 - 7 of 7 posts
Log in to reply.

NICE!
NICE!